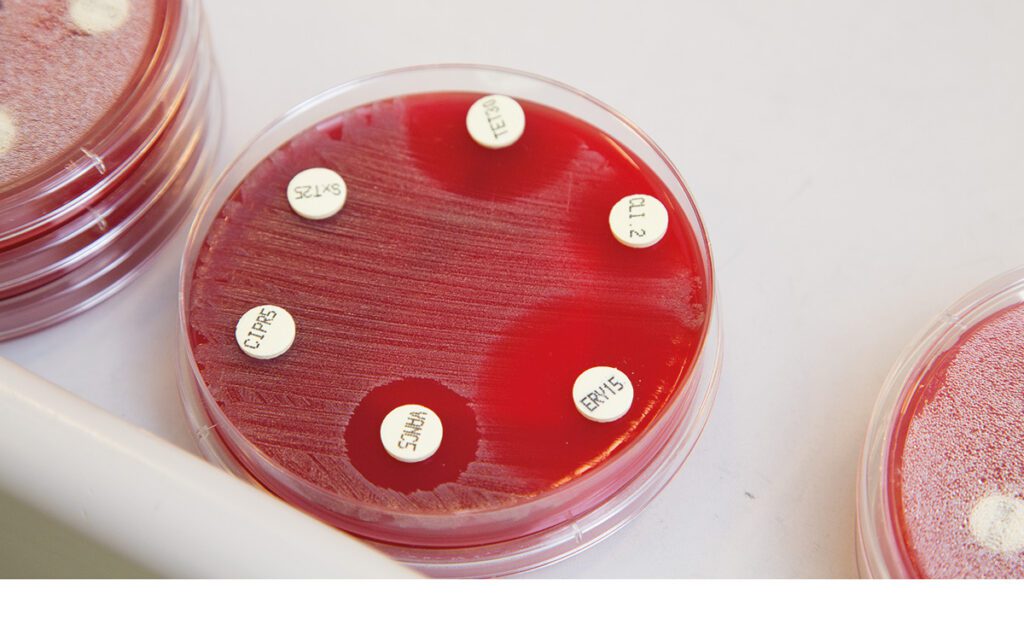

In laboratoria stellen analisten antibioticaresistentie vast met een antibiogram. Deze techniek is de laatste jaren steeds verder uitgebreid en geautomatiseerd. Daarnaast raken technieken zoals MALDI-TOF en sequencing in zwang. Een overzicht van de laatste ontwikkelingen op dit gebied.
tk1 Analisten in klinische laboratoria gebruiken verschillende technieken om bacteriën te identificeren en resistentiepatronen te bepalen. Identificatie van bacteriën gebeurde veelal door enzymatische activiteit te bepalen, bijvoorbeeld met behulp van de bonte rij of API-strips van Biomérieux. Nu worden bacteriën voornamelijk geïdentificeerd op basis van morfologie, eiwitprofiel of genetisch materiaal.
Antibiogram: gevoeligheidsbepaling voor antibioticum
Resistentie wordt bepaald door te testen hoe gevoelig bacteriën zijn voor antibiotica, vaak met een antibiogram. Bij de diskdiffusiemethode worden antibioticaschijfjes op een bacteriekweek geplaatst. Na incubatie wordt de zone zonder groei gemeten. Hoe groter deze zone, hoe gevoeliger de bacterie is voor het antibioticum.
tk2 Geautomatiseerde bepalingen
Tegenwoordig gebeurt de identificatie en antibiogram bepaling van bacteriën grotendeels met deze geautomatiseerde systemen en technieken:
- ADAGIO: Dit systeem van Bio-Rad kan op een geautomatiseerde manier diskdiffusie platen analyseren. Het marktaandeel is beperkt in vergelijking met de andere systemen.
- VITEK: Dit geautomatiseerde systeem van Biomérieux test de gevoeligheid voor een selectie van antibiotica. Het systeem is geschikt voor snelle analyses, maar minder geschikt voor complexe resistentie.
- MALDI-TOF MS (Matrix-Assisted Laser Desorption Ionization – Time of Flight Mass Spectometry): Dit systeem, bijvoorbeeld de Bruker Biotyper, identificeert bacteriën snel op basis van eiwitprofielen en kan soms ook resistentie-eiwitten te detecteren.
- PCR (Polymeric Chain Reaction): Met een PCR-systeem, zoals van Thermo Fisher Scientific, is de aanwezigheid van bekende resistentiegenen, zoals mecA, snel en gevoelig te detecteren.
- Sequencing. Sequencers, zoals die van Illumina, geven volledige genoomanalyse om zowel bekende als nieuwe resistentiegenen te identificeren. Deze kostbare methode is geschikt voor diepgaand resistentieonderzoek.
tk3 Veel laboratoria combineren meerdere technieken om bacteriën nauwkeurig te determineren en resistentie te bepalen. Vooral de VITEK en MALDI-TOF zie je op veel labs terug voor snelle eerste detectie en identificatie. Vervolgens gebruikt men veelal PCR of sequencing voor gedetailleerd onderzoek naar resistentiegenen.